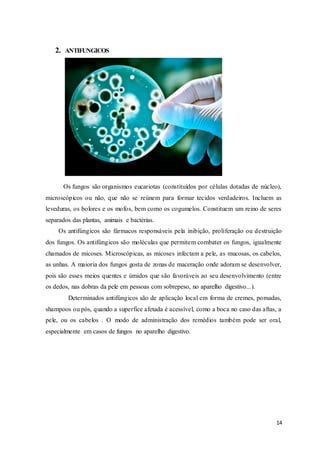
14
2. ANTIFUNGICOS
Os fungos são organismos eucariotas (constituídos por células dotadas de núcleo),
microscópicos ou não, que não se reúnem para formar tecidos verdadeiros. Incluem as
leveduras, os bolores e os mofos, bem como os cogumelos. Constituem um reino de seres
separados das plantas, animais e bactérias.
Os antifúngicos são fármacos responsáveis pela inibição, proliferação ou destruição
dos fungos. Os antifúngicos são moléculas que permitem combater os fungos, igualmente
chamados de micoses. Microscópicas, as micoses infectam a pele, as mucosas, os cabelos,
as unhas. A maioria dos fungos gosta de zonas de maceração onde adoram se desenvolver,
pois são esses meios quentes e úmidos que são favoráveis ao seu desenvolvimento (entre
os dedos, nas dobras da pele em pessoas com sobrepeso, no aparelho digestivo...).
Determinados antifúngicos são de aplicação local em forma de cremes, pomadas,
shampoos ou pós, quando a superfice afetada é acessível, como a boca no caso das aftas, a
pele, ou os cabelos . O modo de administração dos remédios também pode ser oral,
especialmente em casos de fungos no aparelho digestivo.

O documento descreve três classes de medicamentos: antiparasitários, antifúngicos e antivirais. Para cada classe, são apresentados os medicamentos mais procurados nas drogarias e detalhes sobre alguns medicamentos específicos, incluindo composição, farmacocinética, mecanismo de ação, contra-indicações e efeitos colaterais. Os antiparasitários discutidos incluem Anita, Albendazol e Mebendazol. Os antifúngicos abordam Fluconazol e Nistatina. E os antivirais focam em Aciclovir e